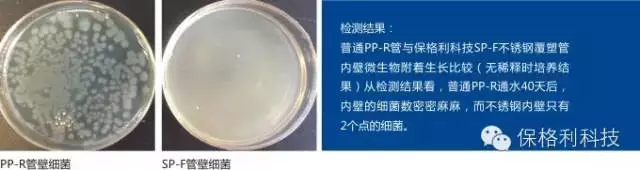
640.webp (5).jpg

夏日暴晒之后自来水为什么会变色?你喝的水是什么颜色的?
2018-09-06 浏览次数:1668次
炎热的夏季来了,当我们拧开龙头的时候水开始变的热;
甚至还会发烫;
如果你家使用的这样的水就要小心了;
夏天来了,你有没有关注过自家的自来水呢?
管道中的青苔跑了出来,瞬间我们回到了水井的年代;
有谁敢百分之百的确定这样的自来水没问题呢?
正如自来水公司一再强调的:“自来水出厂是合格的”
但是却没有考虑到出厂之后的实际情况;
又是管道运输,又是水塔供水,又是二次管道污染
这每一个环节都会出现问题,可是这些环节却一直处于失控状态;
面对家中五颜六色的自来水你敢使用吗;

夏天来了,水管又开始新一轮的滋生;
可惜我们关注的是冷饮,关注的是我们的空调;
对于水,却关注甚少;
水管对水质的改变到底有多大?
你知道家庭水管内部有多脏吗?
如果水管使用3年以上且从未清洗过,
下面就是不同材质水管的内面真相。

PPR塑料水管使用一段时间后,管壁污染严重。是细菌滋生地,成为人类健康杀手和潜在的生命威胁,部分黑心商家为了获取更高的利润,使用废弃塑料盒及工业塑料来做PPR管和普通塑料管,生产出的成品价格低,成为房屋开发商的选择。
2000年四部委下发了通知禁止使用镀锌管做饮用水管的文件,从2001年PPR管和塑料管在我国大面积推广使用,(欧美国家及日本早已不再使用塑料管来做饮用水管了)北京市疾病预防控制中心一份公开的检验报告显示:PPR管和塑料管做饮用水管流出的水质细菌总数是无法计算的,并且肺军团菌1型和5型,数量之多令人震惊。同济大学’清华大学‘上海净水协会’中科院武汉疾病研究所均有论述。
PPR管不宜做饮用水管是管道行业未公开的秘密,PPR管和塑料管没有自洁功能,在我国管网特定的环境下,水资源污染‘工业乱排污’自来水厂工艺落后。
专家建议:对已装修家庭饮用水管更换或者在家庭饮用水管进户安装品牌净水装置,未装修的住宅请您安装(聚丙烯内衬不锈钢自来水管),彻底解决饮用水受塑化剂和细菌的污染,价格是老百姓所能承受,选对水管是关乎人体健康的头等大事。
江苏保格利不锈钢覆塑管构造打破了传统PPR管道及纯不锈钢管道的各种局限,内壁采用SUS304食品级不锈钢,能完全阻挡光线射入,遏制微生物滋生,是国际公认的优质的管道制作材料。管道全程不锈钢等径通水,解决了传统管道二次污染的风险和易爆裂的缺陷。外层复合PPR塑性材料,管材采用了传统塑料管道的热熔方式进行连接,施工简单方便,克服了纯不锈钢管道施工难度高,连接稳定性差的缺陷。二者完美的结合,实现了PPR和不锈钢管的优势互补,创造出具有颠覆性的管道新品。
上海交通大学水质科学与工程实验室测试数据
1.检测方法
中国国家标准方法(GB5749-2006):营养琼脂培养基。37℃,48小时培养计数。美国环保署方法:R2A培养基,28℃,7天培养计数
2.检测结果:普通PP-R通水40天后,内壁细菌培养数密密麻麻,而SUS304不锈钢内壁只有2个菌落数。
3.检测结果对比

自来水管更新换代的时代已来临,保格利SP-F不锈钢覆塑管改善自来水的二次污染,全程不锈钢等径通水无涡流不影响水压流量、坚固抗压、可以做直饮水管,是新一代的健康管道!


